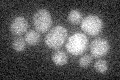
YJL083W
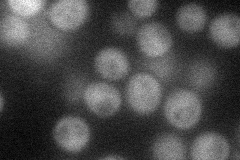
YJL083W
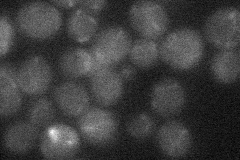
YJL083W
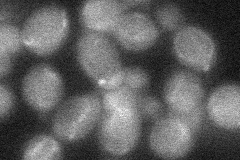
YJL083W
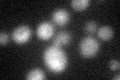
YJL083W
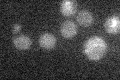
YJL083W

View description
EH domain-containing protein involved in regulating phosphatidylinositol 4,5-bisphosphate levels and autophagy; Irs4p and Tax4p bind and activate the PtdIns phosphatase Inp51p; Irs4p and Tax4p are involved in localizing Atg17p to the PAS
Localization:
Intensity:
Fold change:
Significance:
-
C’ GFP library in SD
below threshold16.16 -
N' NOP1pr-GFP in SD
cytosol36.1291 -
N' TEF2pr-mCherry in SD

below threshold10.2391 -
N' NATIVEpr-GFP in SD
below threshold19.6761 -
N' TEF2pr-VC and Cyto-VN in SD
below threshold26.4958 -
C’ GFP library in SD+DTT
cytosol16.761.03No -
C’ GFP library in SD+H2O2

cytosol16.431.01No -
C’ GFP library in Starvation Media
cytosol16.040.99No -
C’ GFP library on the background of Pup2-DaMP

below threshold -
C’ GFP library on the background of CCT mutant

below threshold17.9911.11285No
